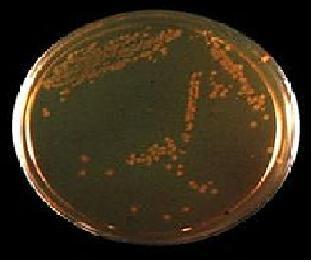
Hektoen Enteric Agar

Hektoen Enteric Agar (HEA) merupakan media selektif-diferensial. Media ini tergolong selektif karena terdiri dari bile salt yang berguna untuk menghambat pertumbuhan bakteri gram positif dan beberapa bakteri gram negatif, sehingga diharapkan bakteri yang tumbuh hanya Salmonella. Media ini digolongkan menjadi media diferensial karena dapat membedakan bakteri Salmonella dengan bakteri lainnya dengan cara memberikan tiga jenis karbohidrat pada media, yaitu laktosa, glukosa, dan salisin, dengan komposisi laktosa yang paling tinggi. Salmonella tidak dapat memfermentasi laktosa, sehingga asam yang dihasilkan hanya sedikit karena hanya berasal dari fermentasi glukosa saja. Hal ini menyebabkan koloni Salmonella akan berwarna hijau-kebiruan karena asam yang dihasilkannya bereaksi dengan indikator yang ada pada media HEA, yaitu fuksin asam dan bromtimol blue.
Sumber: Lihat artikel asli di Wikipedia

Hektoen Enteric Agar (HEA) merupakan media selektif-diferensial.[1] Media ini tergolong selektif karena terdiri dari bile salt yang berguna untuk menghambat pertumbuhan bakteri gram positif dan beberapa bakteri gram negatif, sehingga diharapkan bakteri yang tumbuh hanya Salmonella.[1] Media ini digolongkan menjadi media diferensial karena dapat membedakan bakteri Salmonella dengan bakteri lainnya dengan cara memberikan tiga jenis karbohidrat pada media, yaitu laktosa, glukosa, dan salisin, dengan komposisi laktosa yang paling tinggi.[1] Salmonella tidak dapat memfermentasi laktosa, sehingga asam yang dihasilkan hanya sedikit karena hanya berasal dari fermentasi glukosa saja.[2] Hal ini menyebabkan koloni Salmonella akan berwarna hijau-kebiruan karena asam yang dihasilkannya bereaksi dengan indikator yang ada pada media HEA, yaitu fuksin asam dan bromtimol blue.[2]